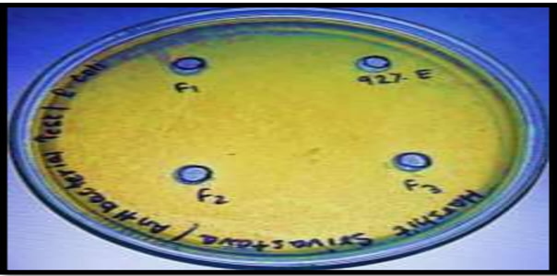

The primary goal of this study was to design and evaluate an effective herbal alcohol-based hand sanitizer formulated with natural ingredients that provide both antimicrobial protection and skin-conditioning benefits. Ethanol (70%) served as the main active ingredient due to its well-documented broad-spectrum antibacterial and antiviral properties. To enhance skin compatibility, 5% aloe vera gel was incorporated for its moisturizing, soothing, and healing effects, making the sanitizer suitable for frequent use. Carbopol was used as the gelling agent to attain the desired consistency, while purified water and rose water acted as diluents and imparted a mild, pleasant fragrance. Glycerine functioned as a humectant, helping to retain skin moisture and counteract the drying effect of alcohol. A small quantity of hydrogen peroxide was added to destroy bacterial spores, adhering to WHO formulation standards. Methyl paraben was included as a preservative to improve the product’s stability and ensure microbial safety. The final formulation was evaluated for parameters such as pH, viscosity, spreadability, stability, and antimicrobial activity against common pathogens. Results indicated that the developed hand sanitizer met standard quality parameters, demonstrated strong antibacterial action, and remained gentle on the skin. Overall, the study highlights the potential of this formulation as a natural, safe, and effective alternative to conventional chemical-based hand sanitizers. The final product was subjected to evaluation based on parameters such as pH, viscosity, spread ability, stability, and antimicrobial effectiveness against common pathogenic microorganisms. Findings confirmed that the hand sanitizer conformed to standard requirements and exhibited notable antibacterial properties while being non-irritating and skin-friendly. This study supports the development of a natural, effective, and safe alternative to commercially available chemical-based hand sanitizers.
Herbal hand sanitizer, Alcohol-based formulation, Aloe vera, antimicrobial activity, Skin-conditioning agents, Natural preservatives
Sanitizers are substances that perform both cleansing and disinfecting functions. Specifically, hand sanitizers are liquid formulations intended for use on living surfaces such as human skin [1], [2]. Maintaining hand hygiene has become a critical element of infection prevention, particularly due to the increasing prevalence of healthcare-associated infections. As medical treatments grow more complex and multidrug-resistant pathogens continue to emerge, healthcare professionals are emphasizing the importance of basic infection control practices—chief among them, proper hand hygiene. Numerous scientific studies have demonstrated that effective hand hygiene greatly reduces the risk of cross-contamination and infection transmission in clinical environments [3].
While washing hands with soap and water remains the most effective method for reducing microbial load, alcohol-based hand sanitizers serve as a practical alternative when soap and water are not available. These sanitizers are effective not only against bacteria and fungi but also against enveloped viruses, including those that cause the common cold and influenza. They also contribute to the prevention of hospital-acquired (nosocomial) infections caused by opportunistic pathogens. Research has shown that alcohol-based hand rubs containing at least 70% alcohol can destroy up to 99.9% of bacteria within 30 seconds and as much as 99.999% within one minute of application [10]. Furthermore, there is a growing interest in natural and herbal-based sanitizing products that incorporate ingredients such as witch hazel, bitter orange peel extract, thyme, and lavender, often combined with organic alcohol. These formulations are gaining popularity for offering mild yet effective antimicrobial cleansing.
MATERIAL AND METHOD
Fresh leaves of Aloe vera (Aloe barbadensis) were collected from the medicinal garden of Sanjivani College of Pharmacy and Research, Kopargaon. The plant material was authenticated by the Department of Pharmacognosy at the same institute. The herbal alcohol-based hand sanitizer was formulated using freshly extracted Aloe vera gel (12–15 ml) as a key ingredient. Other components of the formulation included ethanol (55%–60%), rose water (2–5 ml), carbopol (1 g), glycerin (1 ml), hydrogen peroxide (0.5 ml), purified water (10 ml), and preservatives (1 g), as described in previous studies [22], [23], and [24].
Extraction of Aloe vera Gel
Materials Required:
- Fresh Aloe vera leaves
- Knife or scissors
- Spoon or blunt knife
- Bowl
- Blender (optional)
- Clean, airtight storage container
For the extraction process, fresh Aloe vera leaves were selected and thoroughly cleaned. The outer green rind was carefully removed using a knife or scissors, and the inner transparent gel was gently scooped out with a spoon. The extracted gel was collected in a bowl, blended to obtain a smooth consistency if required, and stored in a clean, airtight container for further use in the formulation.
Procedure:
- Selection and Washing: Choose a healthy, thick leaf from the outer section of the Aloe vera plant. Wash thoroughly to eliminate dirt and contaminants.
- Draining Aloin: Cut the base of the leaf and allow it to stand vertically for 10–15 minutes to drain out the yellowish latex (aloin), which may irritate the skin.
- Peeling the Leaf: Place the leaf on a clean surface, trim the spiky edges, and carefully peel away the upper green skin using a knife or peeler.
- Extracting the Gel: Scoop out the transparent inner gel using a spoon or butter knife and collect it in a bowl.
- Blending (Optional): Blend the gel briefly to obtain a smoother, more uniform texture.
- Storage: Store the gel in an airtight container in the refrigerator. To prolong shelf life, add a few drops of vitamin C or vitamin E oil.
Formulation of Herbal Hand Sanitizer
Formulation Table (Table 6.1.1):
|
Sr. No.
|
Ingredients
|
F1
|
F2
|
F3
|
|
1.
|
Aloe vera gel
|
10 ml
|
11 ml
|
11.5 ml
|
|
2.
|
Carbopol 940
|
1 g
|
1 g
|
1 g
|
|
3.
|
Ethanol
|
9 ml
|
8 ml
|
7.5 ml
|
|
4.
|
Rose water
|
1.5 ml
|
1.5 ml
|
1.5 ml
|
|
5.
|
Glycerin
|
1 ml
|
1 ml
|
1 ml
|
|
6.
|
Hydrogen peroxide
|
1 ml
|
1 ml
|
1 ml
|
|
7.
|
Purified water
|
5.5 ml
|
5.5 ml
|
5.5 ml
|
|
8.
|
Preservatives
|
1 g
|
1 g
|
1 g
|
| |
Total Volume
|
30 ml
|
30 ml
|
30 ml
|
Instruments Used
- Analytical balance
- pH meter
- Brookfield Viscometer
- Magnetic stirrer
- Beakers and measuring cylinders
- Sterile glass containers
- Autoclave
- Incubator
- Sterile cork borer
- Petri dishes
Antimicrobial Activity Screening
Sample Preparation
All ingredients were accurately measured and mixed to form a homogeneous gel. The formulation was stored in sterile containers for microbiological testing.
Test Microorganisms
Bacterial strains:
- Staphylococcus aureus
- Escherichia coli
- Pseudomonas aeruginosa
- Bacillus subtilis
Fungal strains:
- Candida albicans
- Aspergillus niger
Antimicrobial Testing Methods
Sample Preparation
All ingredients were precisely measured and thoroughly mixed to produce a uniform gel. The final formulation was stored in sterile containers for subsequent microbiological testing.
- Test Microorganisms
- Bacterial strains:
- Staphylococcus aureus
- Escherichia coli
- Pseudomonas aeruginosa
- Bacillus subtilis
- Fungal strains:
- Candida albicans
- Aspergillus niger
Antimicrobial Testing Methods
Agar Well Diffusion Method
- Prepare Muller Hinton Agar (MHA) for bacterial cultures and Sabouraud Dextrose Agar (SDA) for fungal cultures.
- Spread microbial suspensions evenly over the agar surface.
- Use a sterile cork borer to create wells in the agar.
- Add the herbal hand sanitizer into the wells.
- Incubate plates at 37°C for 24 hours for bacteria and 25–28°C for 48 hours for fungi.
- Measure the diameter of inhibition zones in millimeters around each well.
Disc Diffusion Method:
- Immerse sterile filter paper discs in the hand sanitizer sample.
- Place the soaked discs on inoculated agar plates.
- Incubate according to the specific microbial strain requirements.
- Measure and record the zones of inhibition.
Minimum Inhibitory Concentration (MIC):
- Prepare serial dilutions of the hand sanitizer in broth.
- Inoculate with the test microorganisms.
- Identify the lowest concentration that prevents visible microbial growth.
Time-Kill Assay:
- Mix the microbial culture with the hand sanitizer.
- Collect samples at 0, 5, 10, 30, and 60 minutes.
- Plate the samples and incubate to assess microbial survival.
- Determine the kill time by comparing colony counts at different time points.
Data Interpretation
- Larger zones of inhibition indicate stronger antimicrobial activity.
- Results were compared against a standard 70% ethanol-based sanitizer used as a positive control.
RESULT AND DISSCUSSION
Formulation Procedure for Herbal Hand Sanitizer
The herbal hand sanitizer was prepared by slowly dispersing Carbopol 940 into distilled water with continuous stirring until a uniform gel base was achieved. The gel was then allowed to hydrate and stabilize for 24 hours. Afterward, a mixture of alcohol and glycerin was added to the hydrated Carbopol gel and blended thoroughly. Herbal extracts were then incorporated into the mixture, followed by the addition of preservatives—methylparaben and propylparaben. The formulation was allowed to rest for one hour before adding hydrogen peroxide. The final hand sanitizer was stored in airtight High-Density Polyethylene (HDPE) containers and subsequently subjected to antimicrobial sensitivity testing.
Evaluation Parameters
- Visual Appearance
The hand sanitizer was evaluated for its clarity, transparency, color, and the presence of any visible particles. A thin layer of the sample was spread on a glass slide and examined under a microscope to detect any grittiness or particulate matter.
Physical Evaluation
- pH Measurement
The pH of the gel was determined using a digital pH meter. One gram of the gel was dispersed in 100 mL of distilled water and left to stand for two hours. Measurements were taken in triplicate, and the average value was recorded.
- Viscosity
Viscosity was measured using a Brookfield viscometer at 37°C with a T-bar spindle (S-94). A 5 g sample placed in a 10 mL beaker was tested at spindle speeds of 50, 60, and 100 rpm, and the readings were recorded 60 seconds after the rotation began.
- Spreadability
Spreadability was assessed using a setup consisting of two glass slides—one fixed and the other movable. The upper slide was attached to a weight via a hook. Spreadability was calculated using the formula:
[S = \frac{m \times l}{t}]
Where m is the weight attached to the upper slide, is the length of the slide, and t is the time taken to separate the slides.
- Antimicrobial Activity
The antimicrobial efficacy was tested against Escherichia coli, Staphylococcus aureus, and Bacillus subtilis and Bacillus subtilis using the agar well diffusion method. Wells were bored in Muller Hinton agar plates, and 100 µL of the sanitizer was added. Streptomycin was used as a reference standard. Plates were incubated at 37°C for 24 hours, and zones of inhibition were measured to evaluate efficacy.
- Clarity Test
Clarity was evaluated by visual inspection to confirm that no particulate matter was present.
- Skin Irritation Test
A small amount of the sanitizer was applied to the palm to observe any signs of irritation or inflammation.
- Stability Study:
The formulated alcohol-based herbal hand sanitizer, containing eucalyptus oil, lemongrass oil, clove oil, and aloe vera gel, was stored for three months. During this period, no changes were observed in its physical appearance, pH, or drug release characteristics.
RESULT AND DISCUSSION:
|
Sr. No.
|
Test Parameter
|
Result
|
|
1
|
Visual appearance
|
|
|
|
Color
|
Colorless to light yellow.
|
|
|
Odor
|
Aromatic and characteristics.
|
|
2
|
pH determination
|
6.61-7.23
|
|
3
|
Viscosity
|
376 cps to 838 cps.
|
|
4
|
Spread-ability
|
6.33 to 7.16 g-cm/sec
|
|
5
|
Antimicrobial study
|
Effective against E.Coli S.aureus B.substilius
|
|
6
|
Clarity test
|
Clear no particular matter
|
|
7
|
Skin irritation test
|
No irritation
|
|
8
|
Stability study
|
Stable for 3 moths (2-8 0 C and 450C)
|
Color: Ranged from colorless to pale yellow.
Odor: Pleasant, aromatic, and characteristic of the essential oils used.
The pH of the formulations ranged between 6.61 and 7.23, which lies within the acceptable range for skin application (5.5–7.0), confirming skin compatibility.
The viscosity of the sanitizer was found to be between 376 to 838 centipoise (cps), suggesting a consistent and user-friendly gel consistency.
The spreadability ranged between 6.33 to 7.16 g·cm/sec, indicating smooth and even application on the skin.
The hand sanitizer showed a viscosity ranging from 6.33 to 7.16 g·cm/sec, reflecting a smooth and uniform consistency. It demonstrated effective antibacterial activity against the tested microorganisms, as evidenced by clear zones of inhibition in the agar diffusion assay. Figures 1 and 2 present the antimicrobial results for the herbal formulation.
Figure no. 1 and 2 illustrate the antimicrobial results, showing the effectiveness of the herbal formulation.
Formulation F1, which included eucalyptus oil, lemongrass oil, clove oil, and aloe vera gel, was stored under different conditions—refrigerated (2–8°C), room temperature (25 ± 2°C), and elevated temperature (45°C)—for three months. Throughout this period, no significant changes were observed in its physical properties, pH, or antimicrobial effectiveness, indicating that the formulation was stable.


 Avhad Sanket*
Avhad Sanket*

10.5281/zenodo.17447985
10.5281/zenodo.17447985